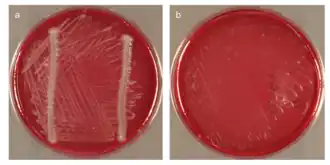
popis obrázku chybí

Chloroflexota
| |
| Vědecká klasifikace | |
| Doména | bakterie (Bacteria) |
| Kmen | Chloroflexota Garrity & Holt, 2001; emend. Hugenholtz & Stackebrandt, 2004 |
| Třídy | |
| |
| Některá data mohou pocházet z datové položky. | |
Chloroflexota[1][2], dříve Chloroflexi, je kmen fotosyntetizujících, převážně vláknitých bakterií, označovaných jako zelené nesirné bakterie. Obvykle mají fotosyntetický zelený pigment ve speciálních tělískách, chlorozomech. Díky těmto barvivům získali své jméno.
Chloroflexota jsou vláknité bakterie, pohybují se zpravidla klouzavým pohybem. Jsou to fakultativní aerobové. Při své fotosyntéze však kyslík neprodukují. Jsou to takzvaní fotoheterotrofové (místo oxidu uhličitého získávají uhlík z organických sloučenin).
Thermomicrobia, dříve zahrnovaná do téhož kmene, jsou v současnosti vyřazovány jako samostatný kmen, nově zvaný Thermomicrobiota.[3]
Reference
V tomto článku byl použit překlad textu z článku Chloroflexi na anglické Wikipedii.
- ↑ OREN, Aharon; GARRITY, George M. Valid publication of the names of forty-two phyla of prokaryotes. International Journal of Systematic and Evolutionary Microbiology [online]. 2021-10-20 [cit. 2024-03-25]. Roč. 71, čís. 10. doi:10.1099/ijsem.0.005056. PMID 34694987. (anglicky)
- ↑ LPSN. Domain Bacteria. Dostupné online (anglicky)
- ↑ http://www.biolib.cz/cz/taxon/id464993/
Externí odkazy
 Obrázky, zvuky či videa k tématu Chloroflexota na Wikimedia Commons
Obrázky, zvuky či videa k tématu Chloroflexota na Wikimedia Commons